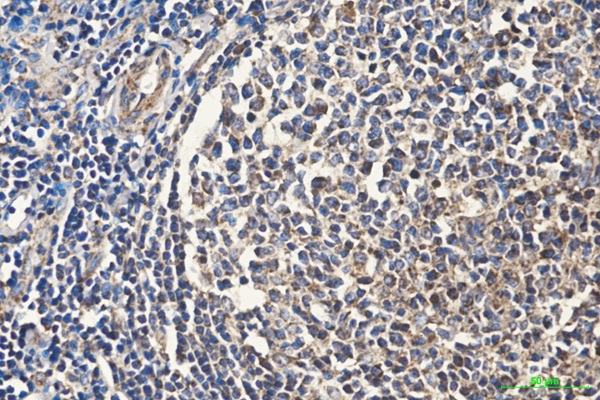

单克隆抗体
Cytochrome C (7C10) Mouse mAb (AB3542)
UniProt:P99999
Application:WB,IHC,ICC/IF
Reactivity:Human,Mouse,Rat,Chicken
Source:Mouse mAb
Cytochrome C (7C10) Mouse mAb (AB3542)
UniProt:P99999
Application:WB,IHC,ICC/IF
Reactivity:Human,Mouse,Rat,Chicken
Source:Mouse mAb
http://www.abways.cn/showproduct.asp?cid=AB3542
HSP70 (1D9) Mouse mAb (AB3544)
UniProt:P08107
Application:WB,IHC,ICC/IF
Reactivity:Human,Mouse,Rat
Source:Mouse mAb
HSP70 (1D9) Mouse mAb (AB3544)
UniProt:P08107
Application:WB,IHC,ICC/IF
Reactivity:Human,Mouse,Rat
Source:Mouse mAb
http://www.abways.cn/showproduct.asp?cid=AB3544
EGFR (3A9) Mouse mAb (AB3545)
UniProt:P00533
Application:WB,IHC,ICC/IF
Reactivity:Human
Source:Mouse mAb
EGFR (3A9) Mouse mAb (AB3545)
UniProt:P00533
Application:WB,IHC,ICC/IF
Reactivity:Human
Source:Mouse mAb
http://www.abways.cn/showproduct.asp?cid=AB3545
Di-Methyl-Histone H3 (Lys79) (8E8) Mouse mAb (AB3546)
UniProt:P68431
Application:WB
Reactivity:Human,Mouse,Rat
Source:Mouse mAb
Di-Methyl-Histone H3 (Lys79) (8E8) Mouse mAb (AB3546)
UniProt:P68431
Application:WB
Reactivity:Human,Mouse,Rat
Source:Mouse mAb
http://www.abways.cn/showproduct.asp?cid=AB3546
TriMethyl-Histone H3 (Lys36) (7G6) Mouse mAb (AB3547)
UniProt:P68431
Application:WB
Reactivity:Human,Mouse,Rat
Source:Mouse mAb
TriMethyl-Histone H3 (Lys36) (7G6) Mouse mAb (AB3547)
UniProt:P68431
Application:WB
Reactivity:Human,Mouse,Rat
Source:Mouse mAb
http://www.abways.cn/showproduct.asp?cid=AB3547

销售咨询
销售咨询 一键电话
一键电话